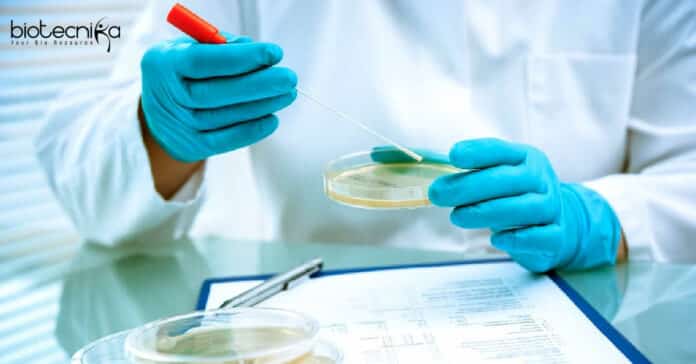

Syngene Quality Executive Job – Life Sciences Apply Online
Syngene Quality Executive Job – Life Sciences Apply Online. Syngene MSc Life Science Job. Check the details on the positions available, the job description, the key responsibilities, work experience, functional experience all below:
Designation: Senior Executive
Job Location: Bangalore
Job ID: 31823
Department: Quality Control-Biologics
Job Description
Key Responsibilities:
- Responsible for preparation of documents such as SOPs, IOPs, EOPs etc.
- Preparation of batch release documents like specifications, STPs with the observation datasheet, verification protocols, method transfer protocols etc.
- Responsible to perform the method transfer analysis and verification activity with documentation for the samples of in-process/finished products.
- Responsible for uploading and assigning SOP / EOP / IOP in LMS.
- Responsible to involve and participate in the preparation and general laboratory readiness for the internal/external / client audits.
- Responsible to complete all planned quality & compliance training as and when required by the department/section or asked by the HOD / Section Head.
- To prepare the complete list of materials (CLM) required for various projects.
- Responsible to initiate and inform immediately to department HOD/designee, if there are any laboratory incidents, deviations, change controls and out of specification results were observed.
- Responsible to conduct any job assigned by the superior.
- Responsible for the training coordinator activity which includes providing training questionnaire, submitting the GTR to archival QA, preparation of JD, training matrix, training binder, review of training files and assigning training in LMS.
- Perform sample management duties which may include movement and storage of samples, reconciliation of sample receipt and aliquoting of samples.
- Responsible for the preparation of stability study-related documents like stability study protocols, observation datasheet, analysis report, stability summary and trend sheets. Responsible for the execution of stability samples charging for the stability study.
- Follow environment, health, and safety (EHS) requirements at all times in the workplace ensuring individual and lab/plant safety.
- Attend training on environment, health, and safety (EHS) measures imparted company.
Educational Qualification: Masters in life sciences (Biochemistry or biotechnology)
Experience: 3 -6 years
Technical Skills:
- Good Knowledge in the execution of all analytical methods related to analysis for Biologics of drug substances / finished products.
- Knowledge of analytical methods of protein, UV spectrophotometer, pH meter usage and writing SOP’s.
- Ample Knowledge on LIMS.
Behavioural Skills:
- Strong commitment towards work, and a high level of dedication, enthusiasm, motivation, and persuasive ability in a team.
- Good speaking-listening-writing skills, attention to detail, proactive self-starter.
- Ability to work successfully in a dynamic, ambiguous environment.
- Ability to meet tight deadlines and prioritize workloads.
- Ability to develop new ideas and creative solutions.
- Should be able to work in a team and flexible for working in shifts.
- Should be a focused employee.
Editor’s Note: Syngene Quality Executive Job – Life Sciences Apply Online. Please make sure that you are subscribed to the Biotecnika Times Newsletter and our YouTube channel to be notified of all of the latest in the industry. Follow us on all of our social media like Twitter, Telegram, Facebook and Instagram.